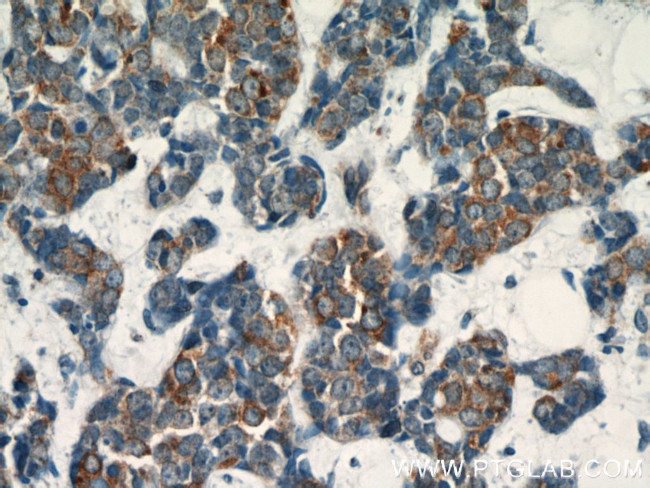
Dysadherin Antibody in Immunohistochemistry (Paraffin) (IHC (P))

Search
Proteintech
Dysadherin Polyclonal Antibody
{{$productOrderCtrl.translations['antibody.pdp.commerceCard.promotion.promotions']}}
{{$productOrderCtrl.translations['antibody.pdp.commerceCard.promotion.viewpromo']}}
{{$productOrderCtrl.translations['antibody.pdp.commerceCard.promotion.promocode']}}: {{promo.promoCode}} {{promo.promoTitle}} {{promo.promoDescription}}. {{$productOrderCtrl.translations['antibody.pdp.commerceCard.promotion.learnmore']}}
产品信息
12166-1-AP
种属反应
宿主/亚型
分类
类型
抗原
偶联物
形式
浓度
规格
纯化类型
保存液
内含物
保存条件
运输条件
产品详细信息
Immunogen sequence: KDTTSSSSA DSTIMDIQVP TRAPDAVYTE LQPTSPTPTW PADETPQPQT QTQQLEGTDG PLVTDPETHK STKAAHPTDD TTTLSERPSP STDVQTDPQT LKPSGFHEDD PFFYDEHTLR KRGLLVAAVL FITGIIILTS GKCRQLSRLC RNHCR (25-178 aa encoded by B C009642)
靶标信息
This gene encodes a member of a family of small membrane proteins that share a 35-amino acid signature sequence domain, beginning with the sequence PFXYD and containing 7 in variant and 6 highly conserved amino acids. The approved human gene nomenclature for the family is FXYD-domain containing ion transport regulator. Mouse FXYD5 has been termed RIC (Related to Ion Channel). FXYD2, also known as the gamma subunit of the Na,K-ATPase, regulates the properties of that enzyme. FXYD1 (phospholemman), FXYD2 (gamma), FXYD3 (MAT-8), FXYD4 (CHIF), and FXYD5 (RIC) have been shown to induce channel activity in experimental expression systems. Transmembrane topology has been established for two family members (FXYD1 and FXYD2), with the N-terminus extracellular and the C-terminus on the cytoplasmic side of the membrane. This gene product, FXYD5, is a glycoprotein that functions in the up-regulation of chemokine production, and it is involved in the reduction of cell adhesion via its ability to down-regulate E-cadherin. It also promotes metastasis, and has been linked to a variety of cancers. Alternative splicing results in multiple transcript variants.
仅用于科研。不用于诊断过程。未经明确授权不得转售。
生物信息学
蛋白别名: Dysadherin; EF-8; FXYD domain-containing ion transport regulator 5; Ion channel homolog RIC; IWU-1; KCT1; keratinocytes associated transmembrane protein 1; Mutations: 15:OK; oncoprotein induced transcript 2; Oncoprotein-induced protein 2; unnamed protein product
基因别名: DYSAD; EF-8; FXYD5; HSPC113; IWU1; KCT1; OIT2; PRO6241; RIC; UNQ2561/PRO6241
UniProt ID: (Human) Q96DB9, (Mouse) P97808
Entrez Gene ID: (Human) 53827, (Mouse) 18301